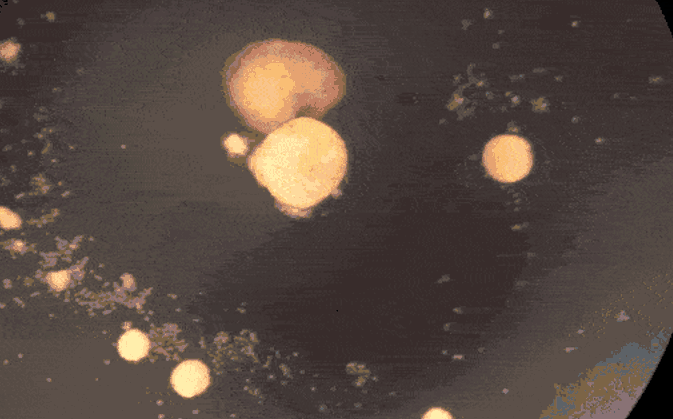
全球首个活体机器人：学会“生娃”，会自我修复，可繁衍四世

整理 | 禾木木
出品 | AI科技大本营(ID:rgznai100)
婴儿活体机器人?确定没有看错!
美国科学家创造了有史以来第一个自我复制的活体机器人 , 也就是说这个活体机器人可以生娃当这些酷似吃豆人的机器人父母在环境中移动时 , 它们会在嘴巴中收集数百个干细胞 。
随着时间的推移 , 这些干细胞会聚集在一起 , 形成机器人宝宝 , 发育成熟之后 , 看起来就像它们的父母一样 。

文章图片
这是由来自佛蒙特大学、塔夫茨大学以及哈佛大学 Wyss研究所的科学家们发现的一种全新的生物繁殖形式 , 并将他们的发现应用于创造了有史以来第一个自我复制的活体机器人 。
目前 , 这项研究已于10月22日发表在 PNAS 上 。 该研究的合著者、塔夫茨大学的资深科学家 Douglas Blackiston 表示 , “长期以来 , 人们一直认为我们已经找到了生命可以繁殖或复制的所有方式 。 但这次我们的发现是之前从未见过的 。 ”
全球首个自我复制活体机器人
去年 , 美国佛蒙特大学和塔夫茨大学的研究者给出了一个否定的答案 。 他们依靠进化算法 , 利用青蛙的表皮细胞和心肌细胞造出了全球首批活体机器人 , 并将其命名为「Xenobot」 。
「Xenobot」不同于传统机器人 , 也不是已知的某种动物物种 , 而是一种新型的、具有生命的、可编程的生物 。 而且 , 它们可以自主移动 , 即使被切开也能够自动愈合 。 「Xenobots」也是世界上第一个能够自我修复和自我复制的人工智能设计的生物机器人 。
非洲爪蟾青蛙的这些胚胎细胞会发育成皮肤 。 “它们会挡在蝌蚪的外面 , 阻挡病原体并重新分配粘液 。 ”研究人员发现“将它们置于一个新的环境中 , 让它们有机会重新利用它们的多细胞性 。 ”
文章图片
这些胚胎细胞要发育的目标与皮肤大不相同 。
“很长一段时间以来 , 人类一直认为我们已经找到了生命可以繁殖或复制的所有方式 , 但这是以前从未观察到的 。 ” Douglas Blackiston 表示 。
“这些青蛙细胞的复制方式与青蛙的复制方式大不相同 。 科学上已知的任何动物或植物都不会以这种方式复制”这项新研究的主要作者 Sam Kriegman 博士说 。
由大约 3,000 个细胞组成的 Xenobot 亲本形成了一个球体 。
这个复制过程最多持续两轮 。 是否会停止取决于适合青蛙胚胎发育的温度范围、解离细胞的浓度、成熟生物的数量和随机行为、溶液的粘度、培养皿的几何形状表面 , 以及污染的可能性 。
“它们可以繁殖 , 但之后系统通常会消亡 。 实际上 , 让系统持续繁殖是非常困难的”Kriegman 说 。
但借助在超级计算机集群上运行的 AI 程序 , 进化算法能够在模拟环境中测试数十亿种体型 , 比如三角形、正方形、金字塔、海星 , 用来找到在基于运动的运动学复制中更有效的细胞 。
爪蟾机器人(Xenobot)能够在培养皿中找到微小的干细胞并将数百个干细胞聚集在「嘴」(指C型的缺口) 里 , 几天后这组干细胞就会裂变成新的爪蟾机器人 。
“我们利用超算弄清楚了如何调整最初父母亲本的形状 。 经过几个月努力 , AI想出了一些奇怪的设计 , 包括一个类似于「吃豆人」的形状 。 这种设计相当违反直觉 , 它看起来很简单 , 但人类工程师想不出来 。 ”Sam Kriegman说 。

特别声明:本站内容均来自网友提供或互联网,仅供参考,请勿用于商业和其他非法用途。如果侵犯了您的权益请与我们联系,我们将在24小时内删除。
